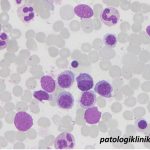
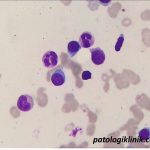
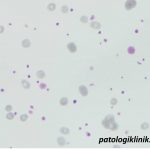
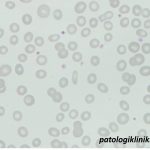

Gambaran Sumsum Tulang pada Myelodysplastic Syndrome (MDS)
Gambaran sumsum tulang yang bisa ditemukan pada pasien MDS di antaranya:
1.Seri eritrosit:
- binukleus
- internuclear bridging
- sisi inti iregular
- perubahan megaloblastoid
- ring sideroblast
- cytoplasmic inclusion
- cytoplasmic bridging
- incomplete hemoglobinization
- fringed cytoplasm
- vakuolisasi
2.Seri leukosit
- pseudo Pelger-Huet
- hipogranulasi netrofil
- hipersegmentasi netrofil
- bizzare nuclear shape
- granula pseudo Chediak-Higashi
3.Seri trombosit
- bentuk monolobus berukuran besar
- small binucleated elements
- dispersed nuclei
- micromegakaryocytes
- degranulasi
Sumber:
Malcovati L, Lindberg EH, BowenD. 2013. Diagnosis and treatment of primary myelodysplastic syndromes in adults: recommendations from the European LeukemiaNet. Blood 122(17); 2943-2963